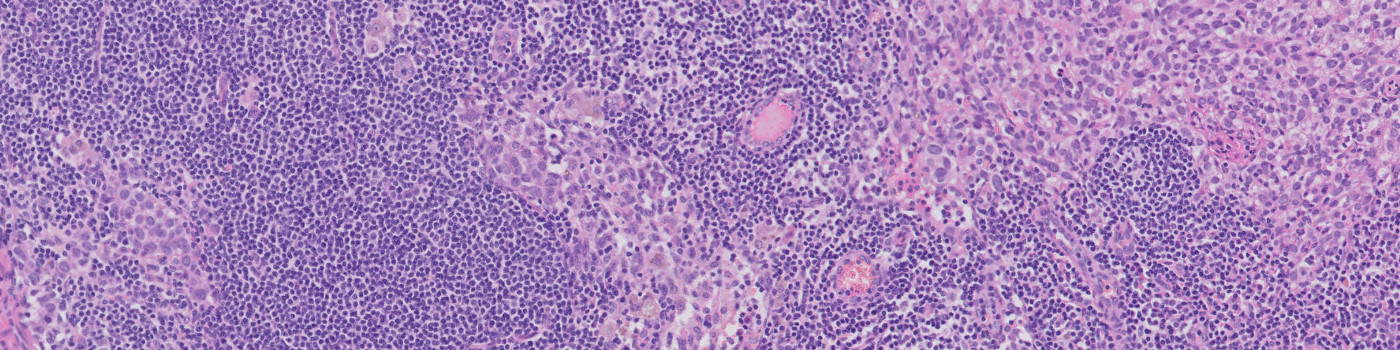
Metastasis Detection, AI

All relevant lymph node tissue is automatically outlined (in purple) for further analysis.

#90159
AI/deep learning-assisted metastasis detection in Lymph nodes – simplifying lymph node assessment.
Metastases in the lymph nodes are a significant indicator of cancer progression, which makes detection critical for treatment decisions. For lymph node assessment pathologists must review many slides per patient which amounts to a significant workload.
Visiopharm has developed a CE IVD certified AI deep learning application that has been trained to detect metastases in H&E stained lymph nodes associated with breast and colorectal adenocarcinoma.
This highly accurate APP enables pathologists to not only detect areas of metastases in lymph nodes. It also measures and orders metastases based on relevant features for either breast or colorectal cancer metastasis (largest metastasis diameter or total area of metastasis).
Verified with clinical samples, the Metastasis Detection APP improves a tedious workflow, and results in improved sensitivity and specificity of metastasis detection in lymph nodes from colorectal and breast adenocarcinoma.
In EU/UK: CE IVD – for use in diagnostic procedures
Benefits from AI-assisted Metastasis detection in your diagnosis workflow
Summary of clinical performance results
Workflow
Visiopharm’s Metastasis Detection APP for whole slide images can easily be integrated into your workflow to become a potential time saver in your review process.